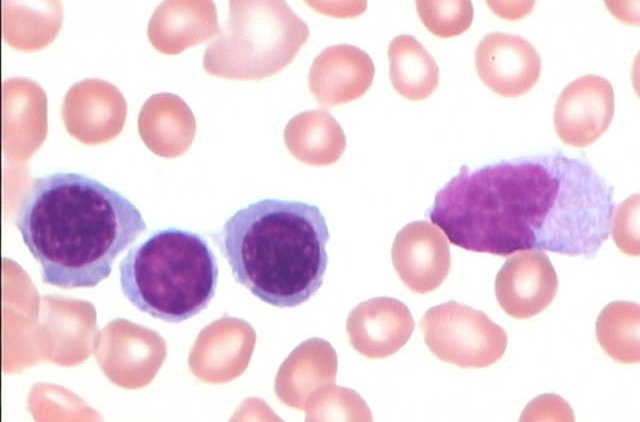
p>单核细胞(monocytes)是血液中最大的 a href="#" data-lemmaid="

单核细胞光镜图

单核细胞
图片尺寸2448x3264单核细胞
图片尺寸1116x1100单核细胞
图片尺寸1109x1100
(图) 原始单核细胞
图片尺寸1104x886单核细胞
图片尺寸1200x900
如何镜下区分淋巴细胞跟单核细胞
图片尺寸2668x2000
论坛
图片尺寸2668x2000
(图) 成熟单核细胞
图片尺寸1115x863单核细胞
图片尺寸1200x900
关节液里的原幼单核细胞
图片尺寸750x516
单核细胞
图片尺寸295x300
脑脊液单核巨噬细胞的别样风情
图片尺寸1080x1070
单核细胞系
图片尺寸315x301
单核细胞,让我们重新认识你!
图片尺寸1280x935
单核细胞
图片尺寸200x196
我的显微镜到位了
图片尺寸770x577
艾滋病引起淋巴细胞和单核细胞变化
图片尺寸390x270
漫漫诊断路——慢性粒单核细胞白血病
图片尺寸1280x800
单核细胞有什么用途
图片尺寸1440x1066p>单核细胞(monocytes)是血液中最大的 a href="#" data-lemmaid="
图片尺寸640x422
猜你喜欢:单核细胞显微镜下图片单核细胞手绘图淋巴细胞光镜图中性粒细胞光镜图单核细胞光镜单核细胞镜下图片单核细胞图淋巴细胞和单核细胞单核细胞镜下单核细胞工作细胞单核细胞图片浆细胞光镜图单核细胞显微镜单核细胞图片显微镜单核细胞图片手绘图原始单核细胞图片单核细胞形态图谱单核细胞巨噬细胞光镜下图片巨噬细胞光镜淋巴细胞光镜嗜酸性粒细胞光镜图原始单核细胞单核细胞形态幼稚单核细胞图片成熟单核细胞淋巴细胞镜下图片单核细胞图片手绘巨噬细胞镜下图片浆细胞光镜怀孕10个月肚子变化图北回归线穿过广东地图罐装50支北京烟女施主69246部队简介巴西雷亚尔人民币格力空调2021促销活动小学毕业照女生黄丹木姜子关于母爱的封面和封底学姐 学长鹏程花园